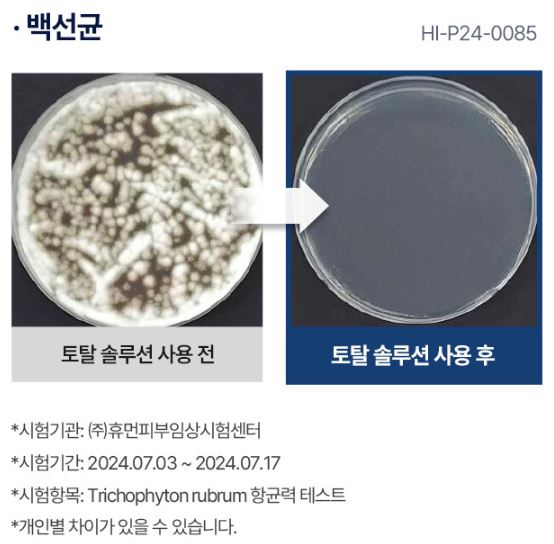
라셀턴 특징 효과

발톱 무좀 때문에 고민 많으셨던 분들이라면 한 번쯤 들어보셨을 "라셀턴 무좀 발톱세럼". 배우 김수로 씨가 직접 모델로 나서며 화제를 모은 이 제품은 실제로도 수많은 소비자들 사이에서 입소문을 타고 있습니다. 이번 포스팅에서는 라셀턴 무좀세럼의 구성 성분, 효과, 사용 후기까지 정확하고 상세하게 살펴보겠습니다.
라셀턴 발톱세럼이란?


정식 제품명은 라셀턴 풋 솔루션 리페어 앰플로, 단순 화장품이 아닌 의약외품으로 식약처 인증을 받은 제품입니다. 라셀턴 무좀약은 브랜드 네이밍 비하인드를 알아보면, 세포를 건강하게 바꾼다는 의미를 담고 있습니다.
- RA: 태양신 '라', 생명력 상징
- CEL: Cell(세포)
- TURN: 변화
라셀턴은 단순히 겉보기만의 피부 개선이 아닌, 피부 본질 문제의 해결을 목표로 합니다. 인체에 유해한 성분은 철저히 배제하고, 자극 없는 식물 유래 성분만을 배합하는 것이 큰 장점입니다.
라셀턴 무좀 발톱 세럼의 핵심 특징
1. 국내 식약처 인증 의약외품
기존 미용 화장품과는 다르게, 손발톱 질환 개선을 위한 항균 기능성 제품으로 인증 받았습니다.
2. 독자적 특허 성분
- 요엽후박나무 추출물
- 티트리 잎 오일
- 라벤더 오일
대한민국 최초로 문제성 발톱 개선에 특허를 받은 조합입니다.
3. 99.9% 항균력 검증
실험 결과, 백선균(무좀 유발균) 감소율 99.9%로 입증!
4. 보습 + 재생 이중케어

- 히알루론산: 수분 공급
- D-판테놀: 피부장벽 강화
- 비오틴: 손톱 영양 공급
왜 라셀턴 발톱세럼이 인기일까?
- 누적 판매량 25만 개 돌파
- 2분마다 1개씩 판매
- 계속되는 완판 기록
- 네일패치 등 확장 제품 출시
무좀으로 손상된 발톱을 단순히 살균하는 데 그치지 않고, 건강한 발톱 재생까지 유도하기 때문에 많은 소비자들의 만족도가 높습니다.
라셀턴 무좀 발톱세럼 성분 집중 분석 성분명 주요 효과


- 히알루론산 깊은 보습, 건조 방지
- D-판테놀 재생 촉진, 피부 보호막 형성
- 비오틴 손발톱 영양 공급 및 변색 방지
- 요엽후박나무 추출물 살균 및 항균 작용
- 라벤더 오일 항염, 항균, 향균 효과
- 자작나무 추출물 항균, 진정, 피부 보습 효과 강화
라셀턴 발톱세럼 사용방법은 미온수로 손/발을 깨끗이 세척 후 완전히 건조시킵니다. 이후 스포이드로 1~2방울 떨어뜨립니다. 발톱 안쪽부터 바깥쪽으로 펴 발라 골고루 흡수시켜 주세요. 하루 2회 아침/저녁 사용 추천.
사용자 생생 라셀턴 후기 모음


실제 사용해보신 분들의 라셀턴 후기를 살펴보면 정말 만족도가 높다는 것을 확인해 볼 수 있는데요. 다음과 같은 대표 라셀턴 후기들을 참고하시면 결정하는데 도움이 될 것입니다.
- 발가락 무좀에 꾸준히 발랐더니 발톱이 깨끗해졌어요. 거품이 올라오는 것도 신기하네요.
- 손에 묻지 않아서 위생적이고 사용하기 편해요. 향도 좋아요!
- 발톱 변색도 걱정됐는데 바르고 점점 투명해지고 있어요.
- 발땀이 많아 늘 무좀 고민했는데, 이 제품 쓰면서 발톱도 튼튼해졌어요.
라셀턴 발톱세럼 가격 정보


현재 정식 판매처 기준으로 할인 시 약 32,000원대(1개월분)에 구입 가능하며, 다양한 구성 패키지가 있으니 공식몰 또는 인증된 판매처에서 혜택 비교 후 구입하는 것이 좋습니다.
| 제품명 | 라셀턴 풋 솔루션 리페어 앰플 |
| 주요 기능 | 무좀균 살균, 발톱 재생, 영양 공급 |
| 핵심 성분 | 티트리오일, 히알루론산, 비오틴 외 |
| 특징 | 식약처 의약외품, 99.9% 항균력 입증 |
| 가격대 | 약 3만 원대 (공식몰 기준) |
팔팔정 50mg, 100mg (발기부전 치료제의 종류)
우리나라 남성들 중 일부는 발기 부전으로 인해 고민하는 경우가 종종 있습니다. 이에 대해, 많은 사람들이 사용하는 발기부전 치료제의 종류중 하나인 팔팔정 효과, 지속 시간, 가격을 알아볼
wikinote.inforank.net
라셀턴 무좀 세럼은 단순한 화장품이 아닌, 의약외품 인증을 받은 손발톱 건강 솔루션입니다. 지금까지의 다양한 후기를 종합해보면, 실제로 꾸준히 사용하면 눈에 띄는 개선 효과를 기대할 수 있으며, 피부 자극이 적은 성분으로 남녀노소 사용 가능하다는 점에서 매우 만족도가 높은 제품이라 할 수 있습니다.
